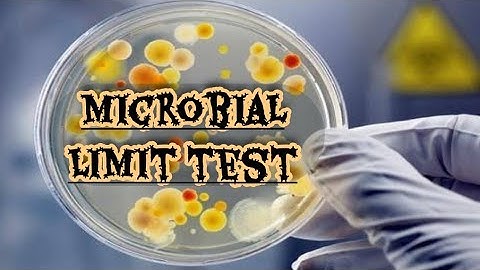
Microbial Limit test (MLT) Protocol, steps and procedure in Pharmaceuticals & cosmetics USP 61 & 62

⬇ DOWNLOAD NOW
Kalau muncul iklan pop-up, tutup lalu klik tombol kembali
Download lagu Microbial Sampling Step 4 - How To Test secara gratis hanya untuk keperluan promosi. Dukung artis favorit kamu dengan membeli musik original di iTunes atau platform resmi lainnya.
Microbial Limit test (MLT) Protocol, steps and procedure in Pharmaceuticals & cosmetics USP 61 & 62
Microbial Limit test (MLT) Protocol, steps and procedure in Pharmaceuticals & cosmetics USP 61 & 62
 4.7.7 Sampling & Confidence: Video
4.7.7 Sampling & Confidence: Video
 Catalase test Biochemical test #lab #microbiology #medtechstudent #laboratory #microbiology #cls #mt
Catalase test Biochemical test #lab #microbiology #medtechstudent #laboratory #microbiology #cls #mt
 Streak plate technique | Shorts | Microbiology
Streak plate technique | Shorts | Microbiology
 How to Collect a MicrobeLink Dx® Bacterial Sample | Easy Step-by-Step Guide
How to Collect a MicrobeLink Dx® Bacterial Sample | Easy Step-by-Step Guide
 Agar plate streaking
Agar plate streaking
 Most Probable Number (MPN) - Microbiology
Most Probable Number (MPN) - Microbiology
 Chicken bacteria under the microscop 😱 #shorts #reels #bacteria #microscope #ytshorts
Chicken bacteria under the microscop 😱 #shorts #reels #bacteria #microscope #ytshorts